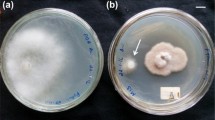

Abstract
Entomopathogenic nematodes (EPN) are well-known as biological control agents and are found to have associated bacteria which can produce a wide range of bioactive secondary metabolites. We report herewith isolation of six proline containing cyclic dipeptides cyclo(d-Pro-l-Leu), cyclo(l-Pro-l-Met), cyclo(d-Pro-l-Phe), cyclo(l-Pro-l-Phe), cyclo(l-Pro-l-Tyr) and cyclo(l-Pro-d-Tyr) from ethyl acetate extract of the Luria Broth (LB) cell free culture filtrate of Bacillus sp. strain N associated with a new EPN Rhabditis sp. from sweet potato weevil grubs collected from Central Tuber Crops Research Institute farm. Antimicrobial studies of these 2,5-diketopiperazines (DKPs) against both medicinally and agriculturally important bacterium and fungi showed potent inhibitory values in the range of μg/mL. Cyclic dipeptides showed significantly higher activity than the commercial fungicide bavistin against agriculturally important fungi, viz., Fusarium oxysporum, Rhizoctonia solani, and Pencillium expansum. The highest activity of 2 μg/mL by cyclo(l-Pro-l-Phe) was recorded against P. expansum, a plant pathogen responsible for causing post harvest decay of stored apples and oranges. To our knowledge, this is the first report on the isolation of these DKPs from Rhabditis EPN bacterial strain Bacillus sp.
Similar content being viewed by others
Avoid common mistakes on your manuscript.
Introduction
Entomopathogenic nematodes (EPN) belonging to the family steinernematidae and heterorhabditidae are one of the most important biocontrol agents against insects pests (Shapiro-Ilan et al. 2006). Xenorhabdus and Photorhabdus are Gram-negative bacteria that live in symbiosis with nematodes (Forst et al. 1997; Burnell and Stock 2000). Bacteria and nematode share a complex life cycle, which includes symbiotic and pathogenic stages. During the symbiotic stage the bacteria are carried in the gut of the nematode, but after infection of an insect host the nematodes inject the bacteria into the insect hemocoel (Yang et al. 2012). Throughout their life cycle, the bacteria and the nematodes produce a variety of metabolites to enable them to colonize and reproduce in the insect host (Toubarro et al. 2009). The metabolites produced include molecules to help evade the insect immune system, enzymes such as proteases, lipases, and phospholipases to maintain a food supply during reproduction (Forst et al. 1997; Thaler et al. 1998; Bowen et al. 2000), antifungal and antibacterial agents to prevent degradation or colonization of the insect carcass while the bacteria and nematodes reproduce (Akhurst 1982; Gaugler and Kaya 1990; Chen et al. 1994). It became obvious that these bacteria are in fact very productive secondary metabolite producers that can produce several structurally diverse compounds having medical and agricultural interest such as antibiotic, antimycotic, insecticidal, nematicidal, antiulceral, antineoplastical and antiviral (Wang et al. 2011). The antimicrobial nature of metabolites produced by Xenorhabdus and Photorhabdus spp. is known, and several of such compounds with antibiotic activity have been isolated and identified. These include indoles (Paul et al. 1981), stilbenes (Hu et al. 1999), xenorhabdins (McInerney et al. 1991a), xenocoumacin (McInerney et al. 1991b), nematophin (Li et al. 1997), benzylineacetone (Ji et al. 2004), xenortides and xenematide (Lang et al. 2008), and cyclolipopeptide (PAX) (Gualtieri et al. 2009). On the other hand, reports on detailed analysis of liquid cultures of the EPN associated bacteria (Brachmann et al. 2006; Lang et al. 2006) clearly indicate their efficiency as producers of several structurally diverse secondary metabolites. Therefore, entomopathogenic bacteria can be regarded as a novel source of potential pharmaceuticals.
During this study on entomopathogenic nematodes we isolated a new EPN Rhabditis sp. from sweet potato weevil grubs collected from Central Tuber Crops Research Institute (CTCRI) farm, Thiruvananthapuram. To our knowledge this is the first time Rhabditis sp. is being studied as an entomopathogenic nematode. A specific bacterium isolated from third stage infective juveniles of the nematode or from the haemolymph of nematode infested Galleria mellonella larvae was found to be pathogenic to a number of insect pests (unpublished results). The antimicrobial substance producing bacterium was isolated from an entomopathogenic, Rhabditis (Oscheius) sp resembling Rhabditis isolate Tumian 2007 at D2 and D3 expansion segments of 28S rDNA (Deepa et al. 2010). Molecular analyses revealed that the bacterium resembles Bacillus sp. (Accession No.CP001407). The bacterium has been deposited in IMTECH (Institute of Microbial Technology, Chandigarh, India) and the accession number is MTCC 5234.
In the present work, we describe the isolation of secondary metabolites produced from Bacillus sp. associated with a new Rhabditid EPN. Detailed structural characterization of the extracted compounds, followed by their potential as antimicrobial agents is tested against diverse Gram-positive, Gram-negative bacteria, and against medicinally and agriculturally important fungi.
Materials and methods
Chemicals and media
All the chemicals used for extraction and column chromatography were of analytical grade and High performance liquid chromatography (HPLC) grade methanol was purchased from Merck Limited, Mumbai, India. Silica gel (230–400 mesh) used for column chromatography and precoated silica gel 60 GF254 plates used for Thin Layer Chromatography (TLC) were purchased from Merck Limited, Germany. Microbiological media was purchased from Hi-Media Laboratories Limited, Mumbai, India. All other reagents were of analytical grade and other chemicals used in this study were of the highest purity. The standard antibiotics ciprofloxacin, and amphotericin B were purchased from Sigma Aldrich. Bavistin fungicide was purchased locally.
Test microorganisms
Gram positive bacteria: Bacillus subtilis MTCC 2756, Staphylococcus aureus MTCC 902; Gram negative bacteria: Escherichia coli MTCC 2622, and Pseudomonas aeruginosa MTCC 2642; medically important fungi: Aspergillus flavus MTCC 183, Candida albicans MTCC 277 and agriculturally important fungi: Fusarium oxysporum MTCC 284, Rhizoctonia solani MTCC 4634, and Penicillium expansum MTCC 2006. All the test microorganisms were obtained from Microbial Type Culture collection Centre and gene bank division of IMTECH, Chandigarh, India.
Fermentation and extraction of bioactive compounds
Bacterial fermentation was carried out using LB medium (tryptone 10 g/L, yeast extract 5 g/L, NaCl 10 g/L. water 1,000 mL) supplemented with 1 % meat peptone. Aliquots of the stock culture were added separately into 100 mL sterile medium. The flasks were incubated in a gyrorotatory shaker (150 rpm) at 30 °C in dark for 24 h. When the optical density of the culture at 600 nm was approx 1.7, the bacterial cultures were transferred aseptically into 400 mL sterile medium and incubated in the gyrorotatory shaker (150 rpm) at 30 °C in dark for 96 h. The culture media were then centrifuged (10,000 rpm, 20 min, 4 °C) followed by filtration through a 0.45 μM filter, to obtain cell free culture filtrate. A 30 L filtrate was treated with ethyl acetate which after concentration led to 9.3 g of crude extract.
Purification of bioactive compounds
The oily yellow residue (9.3 g) was subjected to column chromatography on a silica gel column (25 × 600 mm) previously equilibrated with hexane and eluted successively with 200 mL of 100 % hexane, 200 ml of linear gradient hexane: dichloromethane (v/v, 75:25 to 25:75), 200 mL of 100 % dichloromethane, 200 mL of linear gradient dichloromethane: ethyl acetate (v/v, 99:1 to 1:99), 200 mL of 100 % ethyl acetate and finally with 200 mL of 100 % methanol. Two fractions (100 mL each) were collected from each combination. Six fractions yielded white crystalline compounds which were further purified by crystallization using hexane and benzene and the pure compounds were tested for its purity using HPLC, using LC-10AT liquid chromatograph (LC; Shimadzu, Singapore) equipped with a C-18 column (5 μm, 4.6 × 250 mm) and 100 % methanol as a mobile phase with a flow rate of 1 mL/min. Ultraviolet (UV) detection was carried out with a diode array detector (Shimadzu). The antibacterial activity of the compounds was determined by well diffusion assay against B. subtilis, which was selected as initial test microorganism.
Structure elucidation of bioactive compounds
The structure of the compounds were determined using nuclear magnetic resonance (NMR) spectroscopy (Bruker DRX 500 NMR instrument, Bruker, Rheinstetten, Germany) equipped with a 2.5-mm microprobe. CDCl3 was used as solvent to measure 1H, 13C and 2D NMR experiments and all spectra were recorded at 23 °C. 1H NMR spectra were recorded in CDCl3 using tetramethylsilane (TMS) as internal standard at 500 and 400 MHz, 13C NMR spectra were recorded at 125 and 100 MHz, chemical shifts are given in parts per million and coupling constants in Hz. Chemical shifts are reported relative to the solvent peaks (CDCl3: 1H δ 7.24 and 13C δ 77.23). High resolution mass spectrophotometer (HRMS) data were measured using an electrospray ionization mode of a Thermo Scientific Exactive Orbitrap LC-Mass Spectrometer with ions given in m/z. UV spectra and optical rotations were acquired on a Systronics double beam spectrophotometer 2201 UV–VIS spectrophotometer, India and a Rudolph Research Autopol III polarimeter, respectively. The melting point of the pure compounds were measured with a differential scanning calorimeter (DSC) with a Mettler Toledo DSC 822e instrument (Mettler-Toledo, Schcoerfenbach, Switzerland), and a temperature range of 30–300 °C were employed.
Absolute Configuration Determination of compounds by Marfey’s Method
A solution of DKPs (1.5 mg) in 6 M HCl (1 mL) was heated to 120 °C for 24 h. The solution was then evaporated to dryness and the residue redissolved in H2O (100 μL). A 50 μL aliquot of the acid hydrolysate solution was then treated with a 1 % (w/v) solution of FDAA (200 μL) in acetone. After addition of 1.0 M NaHCO3 (40 μL) the reaction mixture was heated at 45 °C. After 1 h the reaction mixture was cooled to room temperature, and then acidified with 2.0 M HCl (20 μL). Similarly, pertinent amino acids of both d and l forms were derivatized with FDAA separately. The derivatives of the hydrolysates and standard amino acids were then subjected to HPLC analysis using Shimadzu LC-20AD (C18 column; 5 μm, 4.6 × 250 mm; 1.0 mL/min) at 30 °C using the following gradient program: solvent A, water + 0.2 % TFA; solvent B, MeCN; linear gradient 0 min 25 % B, 40 min 60 % B, 45 min 100 % B; UV detection at 340 nm (Marfey 1984).
Antimicrobial activity
Antibacterial activity
The test compounds and antibiotics were screened for antimicrobial activity using the macro dilution method recommended by the Clinical and Laboratory Standards Institute, USA (CLSI 2006). To determine the minimum inhibitory concentrations (MICs), the compounds were dissolved in methanol to give a stock concentration of 2,000 μg/mL while the antibiotics were dissolved in sterile distilled water to give stock concentrations of 1,000 μg/mL. All stock concentrations of compounds and antibiotics were filter sterilized using 0.2 μM syringe filter. Twofold serial dilutions of the antibiotics and compounds were made with nutrient broth to give concentrations ranging from 1 μg/mL to a final concentration of 1,000 μg/mL. Colony suspensions equivalent to a 0.5 McFarland standard were prepared and inoculated onto antibiotic-containing medium to yield a final inoculum of 104 CFU/mL. The tubes were incubated at 35 °C for 24 h. The control tube did not have any antibiotics or test compounds, but contained the test bacteria and the solvent used to dissolve the antibiotics and compounds. The solvent was found to be having no affect on the growth of the bacteria during the experiments. Inhibition of bacterial growth was determined by measuring the absorbance at 600 nm. The MIC was defined as the lowest antibiotic concentration showing no growth. Triplicate sets of tubes were maintained for each concentration of test sample.
Antifungal activity
MIC was determined using potato dextrose agar media against the standard fungicide bavistin by the poisoned food technique (Rollas et al. 1993) against A. flavus, F. oxysporum, R. solani and P. expansum. A stock solution of 2,000 μg/mL of the test compound was prepared, which was further diluted with methanol to give the required concentrations 1–1,000 μg/mL. One tube was used as solvent control. For C. albicans, the broth dilution method (CLSI 2008) was adopted using potato dextrose broth against the standard fungicide amphotericin B. All experiments were performed in triplicate for treatment against each fungus.
Results
Isolation and purification of bioactive compounds
The ethyl acetate extract of the cell free culture filtrate of the bacteria showed antibacterial activity against B. subtilis. Silica gel column chromatography of this extract yielded six crystalline compounds eluted at 2 % ethyl acetate in DCM (DKP 1), 10 % ethyl acetate in DCM (DKP 2), 26 % ethyl acetate in DCM (DKP 3), 41 % ethyl acetate in DCM (DKP 4), 50 % ethyl acetate in DCM (DKP 5) and 60 % ethyl acetate in DCM (DKP 6), respectively. These crystalline compounds were further purified by crystallization using hexane and benzene. Initial bioactivities of these compounds were confirmed by testing against the indicator test microorganism B. subtilis. Thin layer chromatography of the purified compounds in silica gel TLC sheet revealed single spots.
Identification of bioactive compounds
The pure compound was subjected to various analytical methods, i.e. UV, NMR and HRMS. The structure of these six compounds corresponded to six different cyclic dipeptides (DKP 1–6). The cyclic dipeptides identified were cyclo(d-Pro-l-Leu) (DKP 1), cyclo(l-Pro-l-Met) (DKP 2), cyclo(d-Pro-l-Phe) (DKP 3), cyclo(l-Pro-l-Phe) (DKP 4), cyclo(l-Pro-l-Tyr) (DKP 5), and cyclo(l-Pro-d-Tyr) (DKP 6) (Fig. 1). The 1H and 13C NMR spectra in all the DKPs showed the signal at δH 4.10 (t) with J value around 9 Hz with a corresponding δC of 59.0, along with multiplets around δH 2.3, 2.0, and 3.5 ppm, clearly indicating the presence of a proline residue. By comparison of NMR chemical shift, splitting and coupling constant data of standard amino acid residue, it was concluded that DKP 1 contains leucine, and DKP 5 contains tyrosine residues. Based on the observation of a signal due to an amide hydrogen in the NMR spectra of all DKPs, mass spectral data and comparison with standard DKPs, all the cyclic dipeptides presently isolated were found to have proline. Additional spectral information such as HMQC and 1H–1H COSY was required for DKP 2, DKP 3, DKP 4, and DKP 6. HMQC information was used to transfer assigned numbers from carbons in 13C NMR to the protons in 1H NMR. The key COSY cross-peaks between C9-C8, C1-C8, and δH 2.13 (s) in DKP 2 indicated the presence of methionine residue; COSY cross-peaks between C1-C8 and aromatic protons between δH 7.22–7.36 in DKP 3 and DKP 4 indicated the presence of phenylalanine residue; COSY cross-peaks between C1-C8, and δH 6.8 (d, 2H) and 7.0 (d, 2H) in DKP 5 and DKP 6 indicated the presence of tyrosine residue. HPLC analysis of the 1-fluoro-2,4-dinitrophenyl-5-l-alanine amide (FDAA, Marfey’s reagent) FDAA derivatives of the acid hydrolysates of DKPs afforded the similar retention time in HPLC as those prepared from respective L and D amino acids (see supplementary data for HPLC profiles).
DKP 1: cyclo(d-Pro-l-Leu): 21 mg; white powder; R f 0.50 (35 % benzene in acetone); Retention time: 2.816 min (Fig. 2a); Melting point: 162.42 °C (Fig. 3a); [α] 30D +38.4° (c 0.11, EtOH); UV λmax : 210 nm (MeOH); NMR data (Table 1); HRESIMS [M + H]+ C11H19N2O2 calcd for m/z 211.14410, found 211.14408 (Supplementary data).
HPLC chromatogram of cyclic dipeptides on a reversed-phase C18 column (LC-20AD). Samples of 15 μl were injected to a column (250 mm × 4.6 mm × 5 mm), eluted with 100 % methanol. a Cyclo (d-Pro-l-Leu), b cyclo (l-Pro-l-Met), c cyclo (d-Pro-l-Phe), d cyclo (l-Pro-l-Phe), e cyclo (l-Pro-l-Tyr) and f cyclo (l-Pro-d-Tyr). The purity of the compounds reached greater than 90 % according to the peak area
DSC curves of diketopiperazines. Temperatures corresponding to the onset of transition and midpoint of the transition region and enthalpy (∆H) were recorded by means of the built-in software. a Cyclo (d-Pro-l-Leu), b cyclo (l-Pro-l-Met), c cyclo (d-Pro-l-Phe), d cyclo (l-Pro-l-Phe), e cyclo (l-Pro-l-Tyr), and f cyclo (l-Pro-d-Tyr)
DKP 2: cyclo(l-Pro-l-Met): 25 mg; white powder; R f 0.40 (55 % benzene in acetone); Retention time: 2.753 min (Fig. 2b); Melting point: 148.65 °C (Fig. 3b); [α] 30D −85.3° (c 0.10, EtOH); UV λmax : 205 nm (MeOH); NMR data (Table 1); HRESIMS [M + H]+ C10H17N2O2S calcd for m/z 229.10053, found 229.10033 (Supplementary data).
DKP 3: cyclo(d-Pro-l-Phe): 15 mg; white powder; R f 0.48 (70 % benzene in acetone); Retention time: 2.805 min (Fig. 2c); Melting point: 154.88 °C (Fig. 3c); [α] 30D +70.2° (c 0.11, EtOH); UV λmax : 210 nm (MeOH); NMR data (Table 1); HRESIMS [M + H]+ C14H17N2O2 calcd for m/z 245.12845, found 245.12844 (Supplementary data).
DKP 4: cyclo(l-Pro-l-Phe): 18 mg; white powder; R f 0.42 (70 % benzene in acetone); Retention time: 2.705 min (Fig. 2d); Melting point: 165.51 °C (Fig. 3d); [α] 30D −76.9° (c 0.04, EtOH); UV λmax : 208 nm (MeOH); NMR data (Table 1); HRESIMS [M + H]+ C14H17N2O2 calcd for m/z 245.12845, found 245.12844 (Supplementary data).
DKP 5: cyclo(l-Pro-l-Tyr): 20 mg; white powder; R f 0.57 (75 % benzene in acetone); Retention time: 2.679 min (Fig. 2e); Melting point: 145.57 °C (Fig. 3e); [α] 30D −209.0° (c 0.11, EtOH); UV λmax: 229 nm (MeOH); NMR data (Table 1); HRESIMS [M + H]+ C14H17N2O3 calcd for m/z 261.12337, found 261.12325 (Supplementary data).
DKP 6: cyclo(l-Pro-d-Tyr): 16 mg; white powder; R f 0.32 (60 % benzene in acetone); Retention time: 2.845 min (Fig. 2f); Melting point: 103.55 °C (Fig. 3f); [α] 30D −118.0° (c 0.11, EtOH); UV λmax: 278 nm (MeOH); NMR data (Table 1); HRESIMS [M + H]+ C14H17N2O3 calcd for m/z 261.12337, found 261.12333 (Supplementary data).
Antimicrobial activity
The data of antimicrobial activity of DKPs are as shown in Tables 2 and 3. All cyclic dipeptides recorded significantly good activity against test organisms. DKP 4 recorded lowest MIC against E. coli (8 μg/mL). DKP 6 was inhibitory only against gram positive bacteria. DKP 1, 5 and 6 was not active against P. aeruginosa. DKPs showed significantly higher activity against agriculturally important fungi viz. F. oxysporum, R. solani, and P. expansum. The highest activity of 2 μg/mL by DKP 4 was recorded against the plant pathogen P. expansum. All six DKPs 1–6 were found to be having superior antifungal activity than the standard fungicide bavistin against F. oxysporum, R. solani, and P. expansum.
Discussion
2,5-Diketopiperazines or DKPs are cyclic dipeptides derived from head-to-tail, intramolecular cyclization of a linear dipeptide (Anteunis 1978). DKPs containing proline residue is naturally favored as it can easily adopt a cis-amide conformation (Tullberg et al. 2006). The proline residue has been conservative in several DKPs isolated from a variety of bacteria as natural products. In the present study, we have isolated six proline containing cyclic dipeptides (DKPs 1–6) from ethyl acetate extract of the cell free culture filtrate of Bacillus sp. N strain associated with a novel rhabitid entomopathogenic nematode. Cyclic dipeptides have been investigated for their influence in quorum sensing signaling outcomes by screening their efficacy on LuxR-type proteins, dd-DKPs showed strong inhibitory activity against Vibrio anguillarum, and a ll-Cyclo(Pro-Leu) repressed transcription of the aflatoxin production (Campbell et al. 2009; Yan et al. 2004; Fdhila et al. 2003). They have been isolated from microorganisms, sponges and from a variety of tissues and body fluids (Rosa et al. 2003; Ström et al. 2002; Rudi et al. 1994).
Recently it was demonstrated that cyclo(l-Pro-l-Leu) inhibits aflatoxin production from an agriculturally important fungus Aspergillus parasiticus with inhibition at a range of 0.2 mg/mL (Yan et al. 2004). We observed a greater potency against a similar fungus A. flavus with inhibition at 16 μg/mL for cyclo(d-Pro-l-Leu) DKP 1 with an unnatural d-proline amino acid, indicating the importance of chirality of amino acids having an effect on the topography of the three-dimensional structure of the molecule and thus resulting in biased inhibition. However, cyclo(l-Pro-l-Leu) was shown to possess superior MIC of 16 μg/mL (Rhee 2004) over DKP 1 (320 μg/mL) against pathogenic bacteria E. coli. cyclo(l-Pro-l-Met) DKP 2 isolated from P. aeruginosa was shown to have antimicrobial activity against B. subtilis, S. aureus, and Micrococcus luteus (Jayatilake et al. 1996) with little information about the inhibitory studies. We have observed that DKP 2 was potent against B. subtilis and S. aureus with an MIC of 64 and 32 μg/mL against E. coli. DKP 2 also exhibited strong inhibition towards fungi R. solani, P. expansum, and F. oxysporum. cyclo(l-Pro-l-Phe) DKP 4 is attributed with various biological activities including antimicrobial properties (Rhee 2004; Ström et al. 2002; Wang et al. 1999) and our data also support this evidences reported. On the other hand, cyclo(d-Pro-l-Phe) DKP 3 was less explored for its inhibitory potential against pathogenic bacteria and fungi, for e.g., DKP 3 isolated from the symbiont of the fungus-growing ant Cyphomyrmex minutus (Wang et al. 1999) have shown weak antifungal activity in zone of inhibition studies against C. albicans. Our results showed DKP 3 having good inhibitory potential against both bacteria and fungi with remarkable display of activity against P. expansum (4 μg/mL). Antimicrobial activity of cyclo(l-Pro-l-Tyr) DKP 5 was reported against both Gram-positive and Gram-negative bacteria besides fungi (Smaoui et al. 2012). Cain et al. (2003) reported that DKP 5 exhibits MIC of > 0.5 μg/μL against C. albicans, but interestingly we observed an MIC of 32 μg/mL for DKP 5, which is even better than standard fungicide amphotericin B (50 μg/mL). Isolation of cyclo(l-Pro-d-Tyr) DKP 6 from natural source was reported by Huang et al. (2010) from a specie of marine sponge South China Sea Callyspongia sp. Antimicrobial studies of DKP 6 were less explored; however, the present study recorded superior antifungal activity than the standard fungicide bavistin. Li et al. (2011) reported the production of two stereoisomeric cyclic dipeptides, cyclo(L-Tyr-L-Pro) and cyclo(L-Tyr-D-Pro) from a Lactobacillus reuteri strain where cyclo(L-Tyr-L-Pro) is more effective against Staphylococcus aureus which causes menstruation-associated toxic shock syndrome (TSS) in human. Our study also reveals that stereochemistry of the cyclic dipeptides play an important role in the biological activity.
The origin of DKPs has been questioned as they were found to be present in fermentation broths and cultures of yeast, as well as in lichens and fungi (Prasad 1995). It is known that DKPs can be generated via non-enzymatic cyclization of linear dipeptides at extremes of temperature (Holden et al. 1999). In our study, such a possibility of formation of DKPs during the fermentation process was ruled out by heat sterilization and incubation of the LB medium without Bacillus sp. N strain since we did not observe any detection of DKPs in the HPLC profiles of the corresponding ethyl acetate extracts.
Isolation of DKPs 1–6 from Rhabditis EPN bacterial strain Bacillus sp. is a new finding in literature with complete structural characterization. The data presented in this paper for antimicrobial studies encompassed Gram-positive and Gram-negative bacteria, along with medicinally and agriculturally important fungi. DKPs 1, 3 and 4 exhibited MIC between 16 and 32 μg/mL against Gram-positive bacteria B. subtilis and S. aureus. DKP 4 showed strong inhibitory effect against Gram-negative bacteria E. coli (8 μg/mL) and P. aeruginosa (32 μg/mL). DKP 1, 5 and 6 showed better inhibitory results than commercial antibiotics bavistin and amphotericin B against medicinally important fungi A. flavus and C. albicans. The plant pathogen P. expansum which causes post harvest decay of stored apples and oranges, F. oxysporum that causes fusarium wilt, and R. solani associated with plant diseases such as collar rot, root rot etc., were strongly inhibited by all six DKPs 1–6 and the inhibitory activity is superior over the standard antifungal agent bavistin. In addition, antifungal activity of DKPs 1–6 against plant pathogenic fungi F. oxysporum, R. solani and P. expansum is reported here for the first time. The data presented in this paper clearly indicate that our DKPs 1–6 exhibit potent inhibitory values in the range of μg/mL.
Conclusion
The results of the present study show that DKPs exhibit strong effects against agriculturally important fungi in economically low concentrations. DKPs isolated from ethyl acetate extract of Bacillus sp. associated with a novel Rhabitidis EPN can serve as safe and biodegradable substitute over synthetic chemicals which are detrimental to the environment and human health, to control these pathogenic fungi. Therefore, these microbial secondary metabolites can be ideal agents for use as agrochemicals and as potential antifungal agents. This is the first report on the isolation of these DKPs from Rhabditis EPN bacterial strain Bacillus sp.
References
Akhurst RJ (1982) Antibiotic activity of Xenorhabdus spp., bacteria symbiotically associated with insect pathogenic nematodes of the families Hettrorhabditidae and Steinernematidae. J Gen Microbiol 128:3061–3065
Anteunis MJO (1978) The cyclic dipeptides: proper model compounds in peptide research. Bull Soc Chim Belg 87:627–650
Bowen D, Blackburn M, Rocheleau T, Grutzmacher C, Ffrench-Constant RH (2000) Secreted proteases from Photorhabdus luminescens: separation of the extracellular proteases from the insecticidal Tc toxin complexes. Insect Biochem Mol Biol 30:69–74
Brachmann AO, Forst S, Furgani GM, Fodor A, Bode HB (2006) Xenofuranones A and B: phenylpyruvate dimmers from Xenorhabdus szentirmaii. J Nat Prod 69:1830–1832
Burnell AM, Stock SP (2000) Heterorhabditis, Steinernema and their bacterial symbionts lethal pathogens of insects. Nematology 2:31–42
Cain CC, Lee D, Waldo RH, Henry AT, Casida EJ, Wani MC, Wall ME, Oberlies NH, Falkinham JO (2003) Synergistic antimicrobial activity of metabolites produced by a nonobligate bacterial predator. Antimicrob Agents Chemother 47:2113–2117
Campbell J, Lin Q, Geske GD, Blackwell HE (2009) New and unexpected insights into the modulation of LuxR-type quorum sensing by cyclic dipeptides. ACS Chem Biol 4:1051–1059
Chen G, Dunphy GB, Webster JM (1994) Antifungal activity of two Xenorhabdus species and Photorhabdus luminescens, bacteria associated with the nematodes Steinernema species and Heterorhabditis megidis. Biol Control 4:157–162
CLSI, Clinical and Laboratory Standards Institute (2006) Methods for dilution antimicrobial susceptibility tests for bacteria that grow aerobically. CLSI documents M27-S3, Wayne
CLSI, Clinical and Laboratory Standards Institute (2008) Reference methods for broth dilution antifungal susceptibility tests of yeasts. CLSI documents M27-S3, Wayne
Deepa I, Mohandas C, Makesh KT, Siji JV, Prakash KBS, Babu B (2010) Identification of new entomopathogenic nematodes (EPNs) based on sequences of D2–D3 expansion fragments of the 28SrRNA. J Root Crops 36(2):227–232
Fdhila F, Vazquez V, Sanchez JL, Riguera R (2003) DD-Diketopiperazines: antibiotics active against Vibrio anguillarum isolated from marine bacteria associated with cultures of Pecten maximus. J Nat Prod 66:1299–1301
Forst S, Dowds B, Boemare N, Stackebrandt E (1997) Xenorhabdus and Photorhabdus spp. Bugs that kill bugs. Annu Rev Microbiol 51:47–72
Gaugler R, Kaya HK (1990) Entomopathogenic nematodes in biological control. CRC Press, Boca Raton, pp 75–90
Gualtieri M, Aumelasm A, Thaler JO (2009) Identification of a new antimicrobial lysine-rich cyclolipopeptide family from Xenorhabdus nematophila. J Antibiot 62:295–302
Holden MTG, Chhabra SR, de Nys R, Stead P, Bainton NJ, Hill PJ, Manefield M, Kumar N, Labatte M, England D, Rice S, Givskov M, Salmond GPC, Stewartm GSAB, Bycroft BW, Kjelleberg SA, Williams P (1999) Quorum-sensing cross talk: isolation and chemical characterization of cyclic dipeptides from Pseudomonas aeruginosa and other gram negative bacteria. Mol Microbiol 33:1254
Hu K, Li J, Webster JM (1999) Nematicidal metabolites produced by Photorhabdus luminescens (Enterobacteriaceae), bacterial symbiont of entomopathogenic nematodes. Nematology 1:457–469
Huang RM, Ma W, Dong JD, Zhou XF, Xu T, Lee KJ, Yang X, Xu SH, Liu Y (2010) A new 1,4-diazepine from South China Sea marine sponge Callyspongia species. Molecules 15:871–877
Jayatilake GS, Thornton MP, Leonard AC, Grimwade JE, Baker BJ (1996) Metabolites from an Antarctic sponge-associated bacterium, Pseudomonas aeruginosa. J Nat Prod 59:293–296
Ji DJ, Yi YK, Kang GH (2004) Identification of an antibacterial compound, benzylideneacetone, from Xenorhabdus nematophila against major plant-pathogenic bacteria. FEMS Microbiol Lett 239:241–248
Lang G, Kalvelage T, Peters A, Wiese J, Imhoff JF (2006) Linear and cyclic peptides from the entomopathogenic bacterium Xenorhabdus nematophilus. J Nat Prod 71:1074–1077
Lang G, Kalvelage T, Peters A, Wiese J, Imhoff JF (2008) Peptides from the entomopathogenic bacterium Xenorhabdus nematophilus. J Nat Prod 71:1074–1077
Li JX, Chen GH, Webster JM (1997) Nematophin, a novel antimicrobial substance produced by Xenorhabdus nematophilus (Enterobactereaceae). Can J Microbiol 43:770–773
Li J, Wenliang W, Stacey XX, Magarvey NA, McCormick JK (2011) Lactobacillus reuteri-produced cyclic dipeptides quench agr-mediated expression of toxic shock syndrome toxin-1 in staphylococci. PNAS 108:3360–3365
Marfey P (1984) Determination of D-amino acids. II. Use of a bifunctional reagents, 1,5-difluoro-2,4-dinitrobenzene. Carlsberg Res Commun 49:591–596
McInerney BV, Gregson RP, Lacey MJ, Akhurst RJ, Lyons GR, Rhodes SH, Smith DRJ, Engelhardt LM (1991a) Biologically active metabolites from Xenorhabdus spp. Part 1. Dithiolopyrrolone derivatives with antibiotic activity. J Nat Prod 54:774–784
McInerney BV, Taylor WC, Lacey MJ, Akhurst RJ, Gregson RP (1991b) Biologically active metabolites from Xenorhabdus spp. Part 2 Benzopyran-1-one derivatives with gastroprotective activity. J Nat Prod 54:785–795
Paul VJ, Frautschy S, Fenical W, Nealson KH (1981) Antibiotics in microbial ecology, isolation and structure assignment of several new antibacterial compounds from the insect symbiotic bacteria Xenorhabdus spp. J Chem Ecol 7:589–597
Prasad C (1995) Bioactive cyclic dipeptides. Peptides 16:151–164
Rhee KH (2004) Cyclic dipeptides exhibit synergistic, broad spectrum antimicrobial effects and have anti-mutagenic properties. Int J Antimicrob Agents 24:423–427
Rollas S, Kalyoncuoglu N, Sur-Altiner D, Yegenglu Y (1993) 5-(4-Aminophenyl)-4-substituted 2,4-dihydro-3H-1,2,4-triazole-3-thiones: synthesis, antibacterial and antifungal activities. Pharmazie 48:308–309
Rosa SD, Mitova M, Tommonaro G (2003) Marine bacteria associated with sponge as source of cyclic peptides. Biomol Engineering 20:311–316
Rudi A, Kashman Y, Benayahu Y, Schleyer M (1994) Amino acid derivatives from the marine sponge Jaspis digonoxea. J Nat Prod 57:829
Shapiro-Ilan DI, Gouge GH, Piggott SJ, Patterson FJ (2006) Application technology and environmental considerations for use of entomopathogenic nematodes in biological control. Biol Cont 38:124–133
Smaoui S, Mathieu F, Elleuch L, Coppel Y, Merlina G, Karray RI, Mellouli L (2012) Taxonomy, purification and chemical characterization of four bioactive compounds from new Streptomyces sp. TN256 strain. World J Microbiol Biotechnol 28:793–804
Ström K, Sjogren J, Broberg A, Schnurer J (2002) Lactobacillus plantarum MiLAB 393 produces the antifungal cyclic dipeptides cyclo(L-Phe-L-Pro) and cyclo(L-Phe-trans-4-OH-L-pro) and 3-phenyllactic acid. Appl Environ Microbiol 68:4322–4327
Thaler JO, Duvic B, Givaudan A, Boemare N (1998) Isolation and entomotoxic properties of the Xenorhabdus nematophilus F1 lecithinase. Appl Environ Microbiol 64:2367–2373
Toubarro D, Lucena-Robles M, Nascimento G, Costa G, Montiel R, Coelho AV, Simões N (2009) An apoptosis-inducing serine protease secreted by the entomopathogenic nematode Steinernema carpocapsae. Int J Parasitol 39:1319–1320
Tullberg M, Luthman K, Grtli M (2006) Microwave assisted solid-phase synthesis of 2,5-diketopiperazines: solvent and resin dependence. J Comb Chem 8:915–922
Wang Y, Mueller UG, Clardy J (1999) Antifungal diketopiperazines from symbiotic fungus of fungus-growing ant Cyphomyrmex minutus. J Chem Ecol 25:935–941
Wang Y, Fang X, Cheng Y, Zhang X (2011) Manipulation of pH shift to enhance the growth and antibiotic activity of Xenorhabdus nematophila. J Biomed Biotechnol 2011:1–9
Yan PS, Song Y, Sakuno E, Nakajima H, Nakagawa H, Yabe K (2004) Cyclo(Leucyl- L-prolyl) produced by Achromobacter xylosoxidans inhibits aflatoxin production by Aspergillus parasiticus. Appl Environ Microbiol 70:7466–7473
Yang J, Zeng HM, Lin HF, Yang XF, Liu Z, Guo LH, Yuan JJ, Qiu DW (2012) An insecticidal protein from Xenorhabdus budapestensis that results in prophenoloxidase activation in the wax moth, Galleria mellonella. J Invertebr Pathol 110:60–67
Acknowledgments
We are grateful to Dr. R. Srinivas, HOD, NCMS, IICT, Hyderabad for HRMS analysis. This work was funded by Indian council of Medical Research (ICMR).
Author information
Authors and Affiliations
Corresponding author
Electronic supplementary material
Below is the link to the electronic supplementary material.
11274_2012_1189_MOESM1_ESM.doc
Supplementary data includes HRMS of DKPs and HPLC profile of FDAA derivatives of the acid hydrolysates of DKPs 1–6 and respective derivatives of l and d standard amino acids. (DOC 1186 kb)
Rights and permissions
About this article
Cite this article
Kumar, N., Mohandas, C., Nambisan, B. et al. Isolation of proline-based cyclic dipeptides from Bacillus sp. N strain associated with rhabitid entomopathogenic nematode and its antimicrobial properties. World J Microbiol Biotechnol 29, 355–364 (2013). https://doi.org/10.1007/s11274-012-1189-9
Received:
Accepted:
Published:
Issue Date:
DOI: https://doi.org/10.1007/s11274-012-1189-9